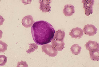

|    |

全登録症例数:225
全登録画像数:1755
全登録画像数:1755
芽球増加を伴う不応性貧血 (RAEB-Ⅰ)は血球減少を主体に以下の形態像を示す。
1)末梢血:芽球は5%未満、アウエル小体(-)、単球は1000/μl未満。
2)骨髄:1~3系統に異形成が10%以上、芽球は5~9%、ア...
(続きを読む) 芽球増加を伴う不応性貧血 (RAEB-Ⅰ)は血球減少を主体に以下の形態像を示す。
1)末梢血:芽球は5%未満、アウエル小体(-)、単球は1000/μl未満。
2)骨髄:1~3系統に異形成が10%以上、芽球は5~9%、アウエル小体(-)。
本例は、重篤な汎血球減少症で、大球性正色素性貧血を呈した。
末梢血に芽球は2%みられ、赤芽球には大型や奇形(涙滴)赤血球がみられた。僅かに巨大血小板を認めた。骨髄の芽球6%(基準が5~9%)はRAEB-Ⅰの範囲内であることと、2系統の形態異常よりMDSの芽球増加を伴う不応性貧血を考え、芽球の割合よりRAEB-Ⅰと診断した。
(たたむ)
1)末梢血:芽球は5%未満、アウエル小体(-)、単球は1000/μl未満。
2)骨髄:1~3系統に異形成が10%以上、芽球は5~9%、ア...
(続きを読む) 芽球増加を伴う不応性貧血 (RAEB-Ⅰ)は血球減少を主体に以下の形態像を示す。
1)末梢血:芽球は5%未満、アウエル小体(-)、単球は1000/μl未満。
2)骨髄:1~3系統に異形成が10%以上、芽球は5~9%、アウエル小体(-)。
本例は、重篤な汎血球減少症で、大球性正色素性貧血を呈した。
末梢血に芽球は2%みられ、赤芽球には大型や奇形(涙滴)赤血球がみられた。僅かに巨大血小板を認めた。骨髄の芽球6%(基準が5~9%)はRAEB-Ⅰの範囲内であることと、2系統の形態異常よりMDSの芽球増加を伴う不応性貧血を考え、芽球の割合よりRAEB-Ⅰと診断した。
(たたむ)
■症例詳細データ
| FAB分類 | > 骨髄異形成症候群 (MDS) > 芽球の増加を伴う不応性貧血 |
|---|---|
| 性別 | 女 |
| 年齢 | 10-14 |
| 取得年代 | 2000-2004 |
| 主訴 | 不正性器出血、汎血球減少。 |
| 既往歴 | 5年前に軽度の汎血球減少を認めるもフォローなし。 |
| 現病歴 | 1ヶ月前より倦怠感を訴え、生理出血が10日間止まらず、婦人科を受診したが婦人科的には異常はなかった。 しかし、汎血球減少を認めたため近医を受診したところ急性白血病の疑いで当科を紹介入院となる。 一般状態不良、眼球結膜(軽度黄染)、眼瞼結膜(蒼白)、口腔内(咽頭発赤軽度)、肝脾腫(-)、リンパ節腫脹(-)。 |
| 検査所見 | WBC 1,150/μl (芽球2, St-Seg38, Ly55, Eo2, Atly3%)、RBC 132万/μl、Hb 4.5g/dl、Ht 14.0%、PLT 4.4万/μl、MCV 106fl、MCH 34.0pg、MCHC 32.1%、 NCC 19.4万/μl、MgK 15.0/μl (芽球6%) PT 66%、APTT 29.5sec、Fbg 287mg/dl、FDP13.3ng/ml、 D-ダイマー 0.37μg/ml、ATⅢ 106%、 TP 5.6g/dl、BUN 6.2mg/dl、AST 18IU/l、ALT 7IU/l、LD 327IU/l、UA 4.1mg/dl、CRP 0.14mg/dl、T.Bil 1.3mg/dl、D-bil 0.6mg/dl、ハプトグロビン 7mg/dl、関節クームス(3+)、不規則抗体Leb抗体(+) |
| 末梢血所見 | 汎血球減少、大球性正色素性貧血の血液像にて芽球は2%みられた。赤芽球には大型や涙滴赤血球がみられた。 僅かに巨大血小板を認めた。 |
| 骨髄所見 | 正形成像にて赤芽球が優位のなか芽球はNEC(赤芽球を除く)中の6%にみられた。 赤芽球には核異型性や巨赤芽球様変化がみられ、血小板系には小型で円形核の巨核球がみられた。 |
| 細胞化学所見 | 芽球はPO染色に陰性で、成熟赤芽球の一部にPAS染色が陽性であった。Fe染色で環状鉄芽球は認めなかった。 |
| 形態診断 | 末梢血の芽球2%(基準は5%未満)、骨髄の芽球6%(基準が5~9%)はRAEB-Ⅰの範囲内であることや2系統に形態異常を認めたことよりMDSの芽球増加を伴う不応性貧血を考え、芽球の割合よりRAEB-Ⅰと診断した。 |
| 免疫学的所見 | CD13・CD33・HLA-DR(+) |
| 分子生物学的所見 | ①46,XX[20] |
| リンパ節所見 | 未施行。 |
| 臨床診断 | 末梢血、骨髄の芽球の割合と2系統の異形成よりMDSのRAEB-Ⅰと診断された。入院後、著明な貧血のためMAP血輸注が開始された。不正性器出血に関しては婦人科にコンサルトしたが特に異常は認められなかった。ハプトグロビンの低下など溶血性貧血も疑われたためγグロブリンが投与された。投与10日後頃から不正出血は止まり貧血の進行は治まった。4日後発熱(38℃)と会陰部の膿化診を認めたためFMOXが開始された。 感染症の軽快につれハプトグロビンの回復を認めた。 今後は溶血性貧血の存在も考慮し白血病への転化を考え外来フォローとなった。 |